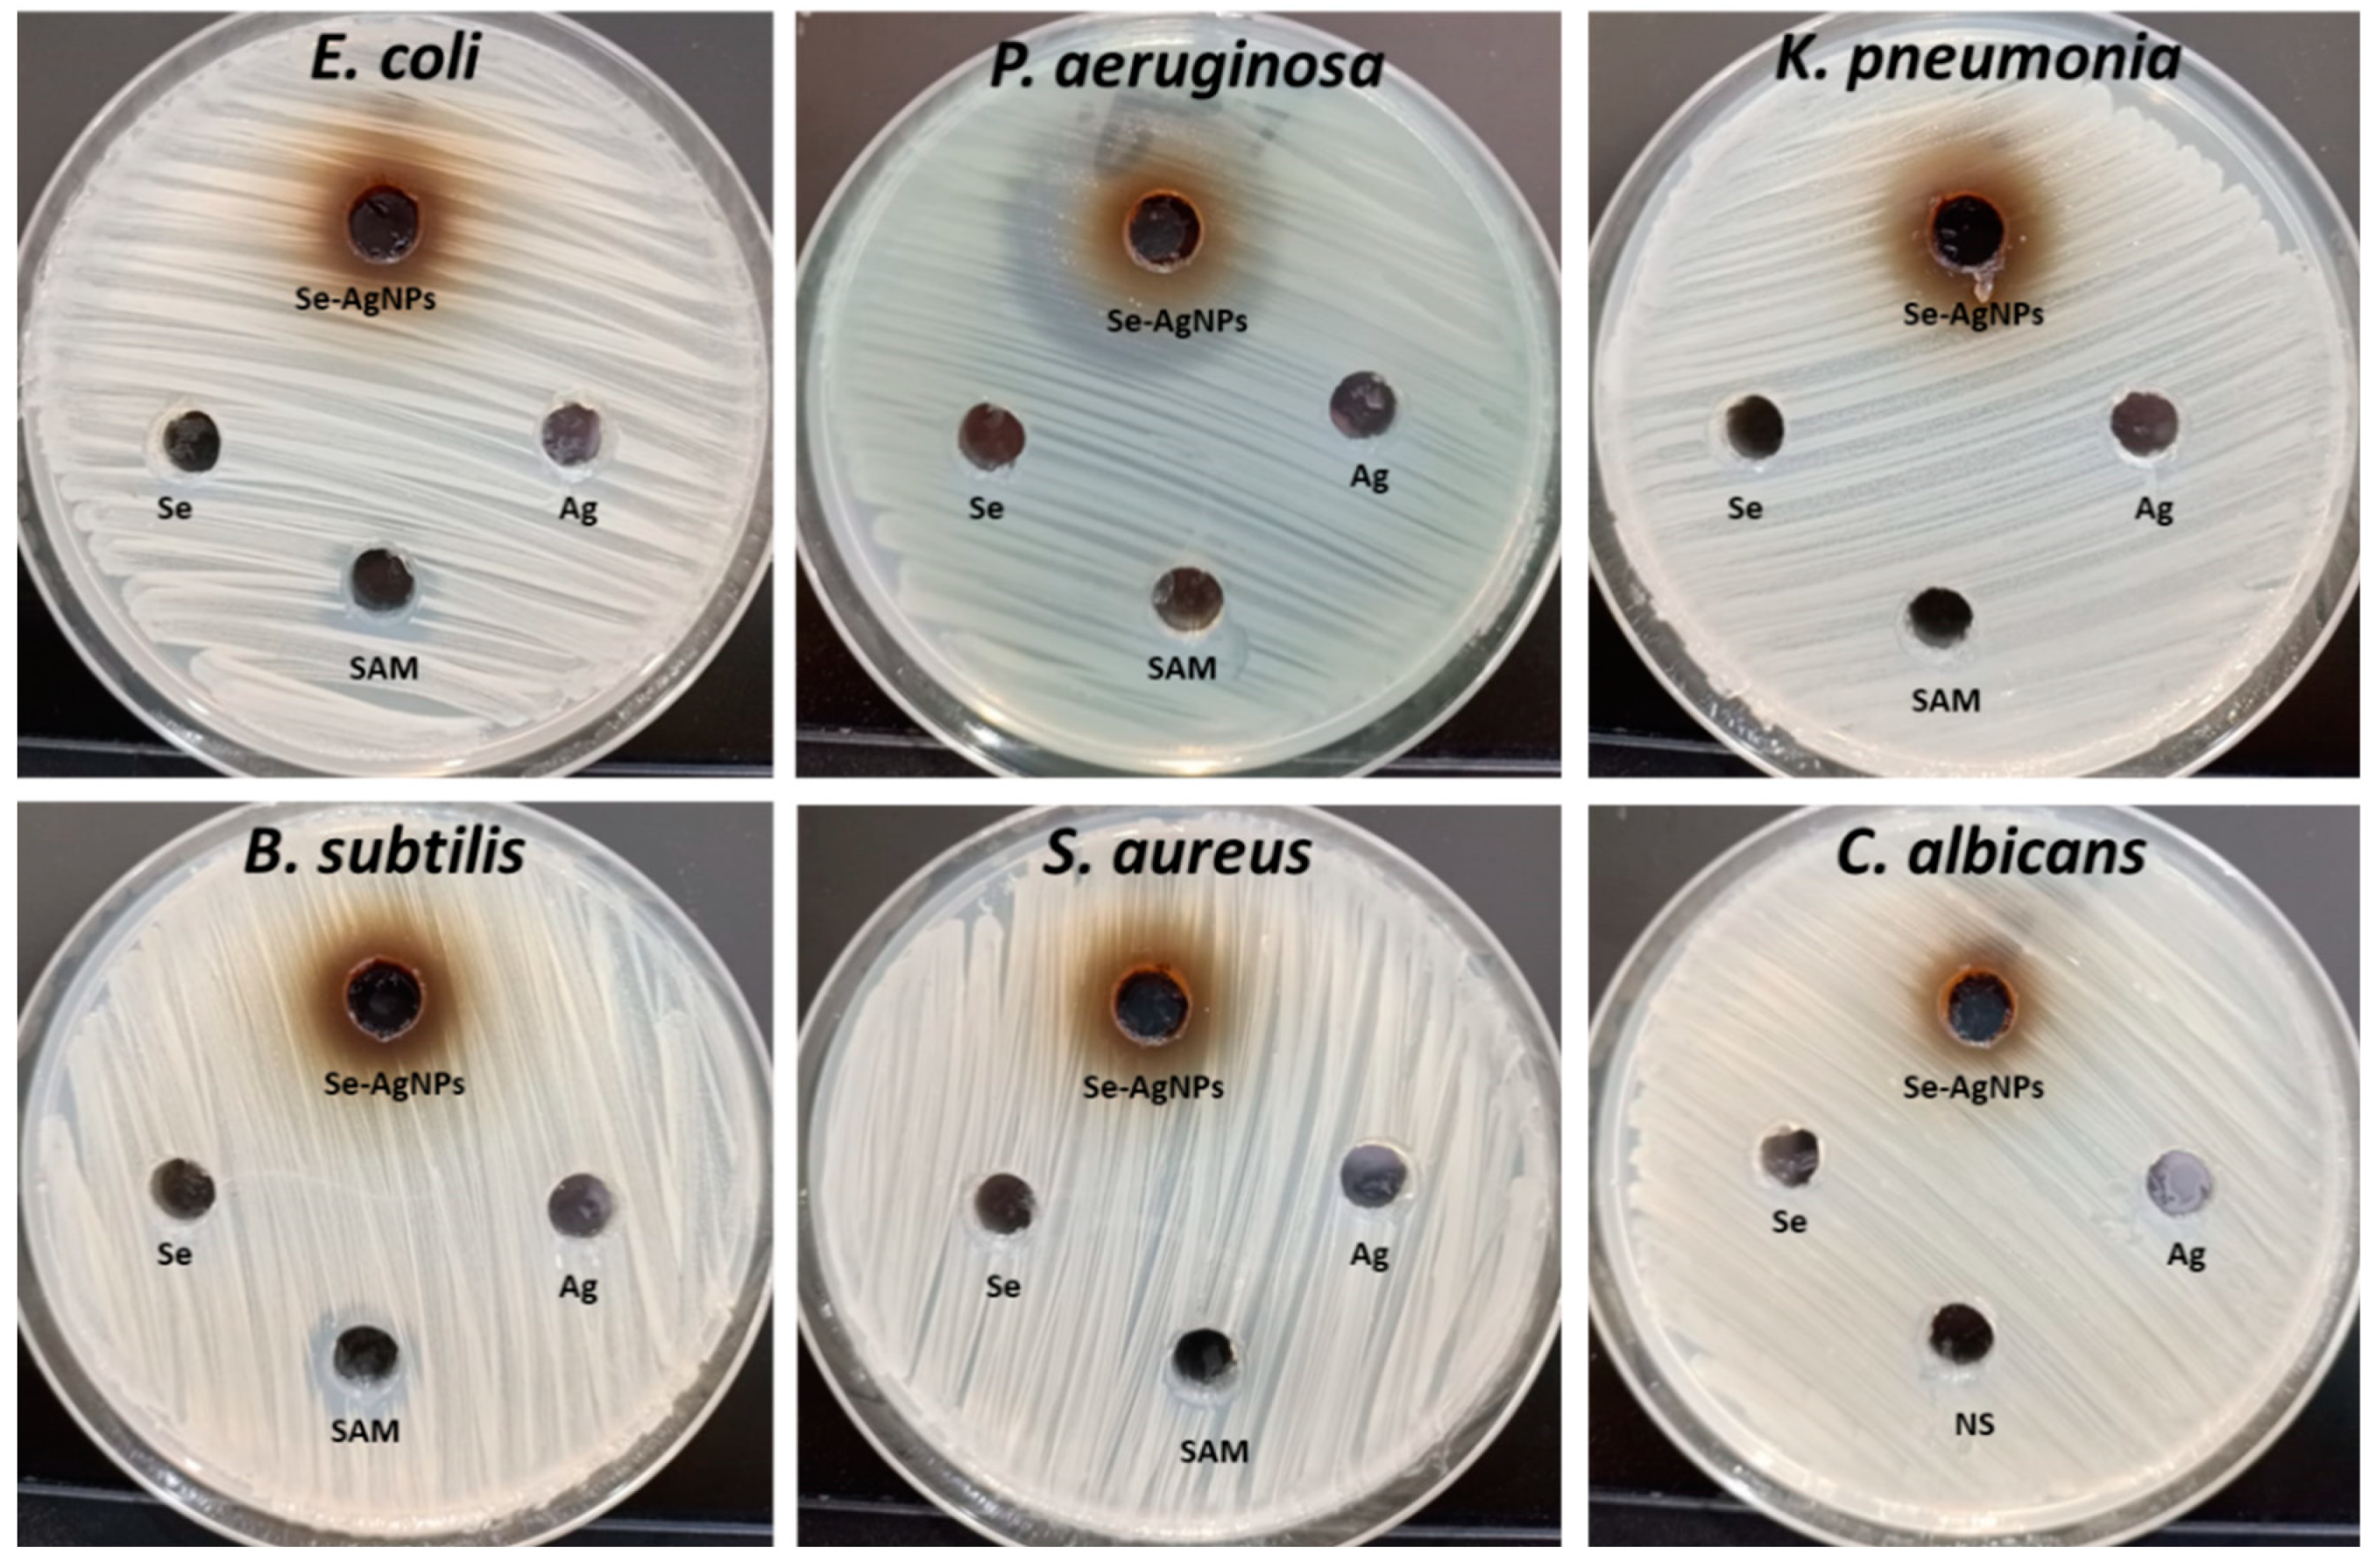
Plants 12 03288 g006

Watermelon Rind Mediated Biosynthesis of Bimetallic Selenium-Silver Nanoparticles: Characterization, Antimicrobial and Anticancer Activities
Abstract
:1. Introduction
2. Results and Discussion
2.1. Biosynthesis of Bimetallic Se-Ag NPs Using WR
2.2. Characterization of the Biosynthesized Se-Ag BNPs
2.2.1. UV-Vis
2.2.2. TEM and DLS Analysis
2.2.3. SEM and EDX Mapping Analysis
2.2.4. SEM/EDX Elemental Mapping Analysis of Bimetallic Se-Ag NPs
2.2.5. XRD Analysis and FTIR Determination
2.3. Antimicrobial Activity
2.4. Cytotoxicity and Anticancer Activity
3. Materials and Methods
3.1. Materials
3.2. Preparation of Watermelon Rind Extract
3.3. Green Biosynthesis of Se-Ag BNPs
3.4. Characterization of Se-Ag NPs BNPs
3.5. Antimicrobial Activity
3.6. In Vitro Cytotoxicity and Anticancer Activity
4. Conclusions
Author Contributions
Funding
Institutional Review Board Statement
Informed Consent Statement
Data Availability Statement
Acknowledgments
Conflicts of Interest
References
- Prestinaci, F.; Pezzotti, P.; Pantosti, A. Antimicrobial resistance: A global multifaceted phenomenon. Pathog. Glob. Health 2015, 109, 309–318. [Google Scholar] [CrossRef]
- Colson, A.R.; Morton, A.; Årdal, C.; Chalkidou, K.; Davies, S.C.; Garrison, L.P.; Jit, M.; Laxminarayan, R.; Megiddo, I.; Morel, C.; et al. Antimicrobial Resistance: Is Health Technology Assessment Part of the Solution or Part of the Problem? Value Health 2021, 24, 1828–1834. [Google Scholar] [CrossRef] [PubMed]
- Catalano, A.; Iacopetta, D.; Ceramella, J.; Scumaci, D.; Giuzio, F.; Saturnino, C.; Aquaro, S.; Rosano, C.; Sinicropi, M.S. Multidrug Resistance (MDR): A Widespread Phenomenon in Pharmacological Therapies. Molecules 2022, 27, 616. [Google Scholar] [CrossRef] [PubMed]
- Ventola, C.L. The antibiotic resistance crisis: Part 1: Causes and threats. Pharm. Ther. 2015, 40, 277. [Google Scholar]
- Bhattacharjee, R.; Negi, A.; Bhattacharya, B.; Dey, T.; Mitra, P.; Preetam, S.; Kumar, L.; Kar, S.; Das, S.S.; Iqbal, D.; et al. Nanotheranostics to target antibiotic-resistant bacteria: Strategies and applications. OpenNano 2023, 11, 100138. [Google Scholar] [CrossRef]
- Kamaruzaman, N.H.; Noor, N.N.M.; Mohamed, R.M.S.R.; Al-Gheethi, A.; Ponnusamy, S.K.; Sharma, A.; Vo, D.-V.N. Applicability of bio-synthesized nanoparticles in fungal secondary metabolites products and plant extracts for eliminating antibiotic-resistant bacteria risks in non-clinical environments. Environ. Res. 2022, 209, 112831. [Google Scholar] [CrossRef]
- Sánchez-López, E.; Gomes, D.; Esteruelas, G.; Bonilla, L.; Lopez-Machado, A.L.; Galindo, R.; Cano, A.; Espina, M.; Ettcheto, M.; Camins, A.; et al. Metal-based nanoparticles as antimicrobial agents: An overview. Nanomaterials 2020, 10, 292. [Google Scholar] [CrossRef] [PubMed]
- Nasrollahzadeh, M.; Sajadi, S.M.; Sajjadi, M.; Issaabadi, Z. An introduction to nanotechnology. In Interface Science and Technology; Elsevier: Amsterdam, The Netherlands, 2019; Volume 28, pp. 1–27. [Google Scholar]
- Zhao, Y.; Zhang, Z.; Pan, Z.; Liu, Y. Advanced bioactive nanomaterials for biomedical applications. Exploration 2021, 1, 20210089. [Google Scholar] [CrossRef] [PubMed]
- Brar, K.K.; Magdouli, S.; Othmani, A.; Ghanei, J.; Narisetty, V.; Sindhu, R.; Binod, P.; Pugazhendhi, A.; Awasthi, M.K.; Pandey, A. Green route for recycling of low-cost waste resources for the biosynthesis of nanoparticles (NPs) and nanomaterials (NMs)-A review. Environ. Res. 2022, 207, 112202. [Google Scholar] [CrossRef]
- Meral, R.; Kose, Y.E.; Ceylan, Z.; Cavidoglu, İ. The potential use of agro-industrial by-products as sources of bioactive compounds: A nanotechnological approach. Stud. Nat. Prod. Chem. 2022, 73, 435–466. [Google Scholar]
- Thangadurai, D.; Naik, J.; Sangeetha, J.; Al-Tawaha, A.R.M.S.; Adetunji, C.O.; Islam, S.; David, M.; Shettar, A.K.; Adetunji, J.B. Nanomaterials from agrowastes: Past, present, and the future. In Handbook of Nanomaterials and Nanocomposites for Energy and Environmental Applications; Springer: Berlin, Germany, 2021; pp. 471–487. [Google Scholar]
- Rini, A.S.; Adzani, H.; Husain, T.; Deraf, M.P.; Rati, Y.; Hamzah, Y. Structural and morphological studies of silver nanoparticles prepared using Citrullus lanatus rind extract. AIP Conf. Proc. 2021, 2320, 030010. [Google Scholar]
- Rini, A.S.; Rati, Y.; Fadillah, R.; Farma, R.; Umar, L.; Soerbakti, Y. Improved Photocatalytic Activity of ZnO Film Prepared via Green Synthesis Method Using Red Watermelon Rind Extract. Evergreen 2022, 9, 1046–1055. [Google Scholar] [CrossRef]
- Nadeem, M.; Navida, M.; Ameer, K.; Iqbal, A.; Malik, F.; Nadeem, M.A.; Fatima, H.; Ahmed, A.; Din, A. A comprehensive review on the watermelon phytochemical profile and their bioactive and therapeutic effects. Korean J. Food Preserv. 2022, 29, 546–576. [Google Scholar] [CrossRef]
- Zia, S.; Khan, M.R.; Shabbir, M.A.; Aadil, R.M. An update on functional, nutraceutical and industrial applications of watermelon by-products: A comprehensive review. Trends Food Sci. Technol. 2021, 114, 275–291. [Google Scholar] [CrossRef]
- Basavegowda, N.; Baek, K.-H. Multimetallic nanoparticles as alternative antimicrobial agents: Challenges and perspectives. Molecules 2021, 26, 912. [Google Scholar] [CrossRef] [PubMed]
- Ifijen, I.H.; Maliki, M.; Anegbe, B. Synthesis, Photocatalytic Degradation and Antibacterial Properties of Selenium or Silver Doped Zinc Oxide Nanoparticles: A Detailed Review. OpenNano 2022, 8, 100082. [Google Scholar] [CrossRef]
- Batra, H.; Pawar, S.; Bahl, D. Curcumin in combination with anti-cancer drugs: A nanomedicine review. Pharmacol. Res. 2019, 139, 91–105. [Google Scholar] [CrossRef]
- Barchielli, G.; Capperucci, A.; Tanini, D. The role of selenium in pathologies: An updated review. Antioxidants 2022, 11, 251. [Google Scholar] [CrossRef]
- Olawale, F.; Ariatti, M.; Singh, M. Ocimum tenuiflorum L. mediated green synthesis of silver and selenium nanoparticles: Antioxidant activity, cytotoxicity and density functional theory studies. Adv. Nat. Sci. Nanosci. Nanotechnol. 2022, 13, 015015. [Google Scholar] [CrossRef]
- Krishnaraj, C.; Radhakrishnan, S.; Ramachandran, R.; Ramesh, T.; Kim, B.-S.; Yun, S.-I. In Vitro toxicological assessment and biosensing potential of bioinspired chitosan nanoparticles, selenium nanoparticles, chitosan/selenium nanocomposites, silver nanoparticles and chitosan/silver nanocomposites. Chemosphere 2022, 301, 134790. [Google Scholar] [CrossRef]
- Vetchinkina, E.; Loshchinina, E.; Kupryashina, M.; Burov, A.; Nikitina, V. Shape and size diversity of gold, silver, selenium, and silica nanoparticles prepared by green synthesis using fungi and bacteria. Ind. Eng. Chem. Res. 2019, 58, 17207–17218. [Google Scholar] [CrossRef]
- Bafghi, M.H.; Darroudi, M.; Zargar, M.; Zarrinfar, H.; Nazari, R. Biosynthesis of selenium nanoparticles by Aspergillus flavus and Candida albicans for antifungal applications. Micro Nano Lett. 2021, 16, 656–669. [Google Scholar] [CrossRef]
- Hashem, A.H.; Saied, E.; Ali, O.M.; Selim, S.; Al Jaouni, S.K.; Elkady, F.M.; El-Sayyad, G.S. Pomegranate peel extract stabilized selenium nanoparticles synthesis: Promising antimicrobial potential, antioxidant activity, biocompatibility, and hemocompatibility. Appl. Biochem. Biotechnol. 2023, 1–24. [Google Scholar] [CrossRef] [PubMed]
- Noori, M.T.; Tiwari, B.; Ghangrekar, M.; Min, B. Azadirachta indica leaf-extract-assisted synthesis of CoO–NiO mixed metal oxide for application in a microbial fuel cell as a cathode catalyst. Sustain. Energy Fuels 2019, 3, 3430–3440. [Google Scholar] [CrossRef]
- Hamidian, K.; Sarani, M.; Sheikhi, E.; Khatami, M. Cytotoxicity evaluation of green synthesized ZnO and Ag-doped ZnO nanoparticles on brain glioblastoma cells. J. Mol. Struct. 2022, 1251, 131962. [Google Scholar] [CrossRef]
- Hussain, N.; Pu, H.; Sun, D.-W. Core size optimized silver coated gold nanoparticles for rapid screening of tricyclazole and thiram residues in pear extracts using SERS. Food Chem. 2021, 350, 129025. [Google Scholar] [CrossRef] [PubMed]
- Nadaf, S.J.; Jadhav, N.R.; Naikwadi, H.S.; Savekar, P.L.; Sapkal, I.D.; Kambli, M.M.; Desai, I.A. Green synthesis of gold and silver nanoparticles: Updates on research, patents, and future prospects. OpenNano 2022, 8, 100076. [Google Scholar] [CrossRef]
- Elfalleh, W.; Hannachi, H.; Tlili, N.; Yahia, Y.; Nasri, N.; Ferchichi, A. Total phenolic contents and antioxidant activities of pomegranate peel, seed, leaf and flower. J. Med. Plants Res. 2012, 6, 4724–4730. [Google Scholar] [CrossRef]
- Shafey, A.M.E. Green synthesis of metal and metal oxide nanoparticles from plant leaf extracts and their applications: A review. Green Process. Synth. 2020, 9, 304–339. [Google Scholar] [CrossRef]
- Ndikau, M.; Noah, N.M.; Andala, D.M.; Masika, E. Green synthesis and characterization of silver nanoparticles using Citrullus lanatus fruit rind extract. Int. J. Anal. Chem. 2017, 2017, 8108504. [Google Scholar] [CrossRef]
- Patra, J.K.; Das, G.; Baek, K.-H. Phyto-mediated biosynthesis of silver nanoparticles using the rind extract of watermelon (Citrullus lanatus) under photo-catalyzed condition and investigation of its antibacterial, anticandidal and antioxidant efficacy. J. Photochem. Photobiol. B Biol. 2016, 161, 200–210. [Google Scholar] [CrossRef]
- Mittal, A.K.; Banerjee, U.C. In Vivo safety, toxicity, biocompatibility and anti-tumour efficacy of bioinspired silver and selenium nanoparticles. Mater. Today Commun. 2021, 26, 102001. [Google Scholar] [CrossRef]
- Berta, L.; Coman, N.-A.; Rusu, A.; Tanase, C. A review on plant-mediated synthesis of bimetallic nanoparticles, characterisation and their biological applications. Materials 2021, 14, 7677. [Google Scholar] [CrossRef] [PubMed]
- Godipurge, S.; Yallappa, S.; Biradar, N.J.; Biradar, J.; Dhananjaya, B.; Hegde, G.; Jagadish, K.; Hegde, G. A facile and green strategy for the synthesis of Au, Ag and Au–Ag alloy nanoparticles using aerial parts of R. hypocrateriformis extract and their biological evaluation. Enzym. Microb. Technol. 2016, 95, 174–184. [Google Scholar] [CrossRef] [PubMed]
- Mostafa, Y.S.; Alamri, S.A.; Alrumman, S.A.; Hashem, M.; Baka, Z.A. Green synthesis of silver nanoparticles using pomegranate and orange peel extracts and their antifungal activity against Alternaria solani, the causal agent of early blight disease of tomato. Plants 2021, 10, 2363. [Google Scholar] [CrossRef]
- Salem, M.F.; Abd-Elraoof, W.A.; Tayel, A.A.; Alzuaibr, F.M.; Abonama, O.M. Antifungal application of biosynthesized selenium nanoparticles with pomegranate peels and nanochitosan as edible coatings for citrus green mold protection. J. Nanobiotechnol. 2022, 20, 182. [Google Scholar] [CrossRef]
- Fardsadegh, B.; Jafarizadeh-Malmiri, H. Aloe vera leaf extract mediated green synthesis of selenium nanoparticles and assessment of their in vitro antimicrobial activity against spoilage fungi and pathogenic bacteria strains. Green Process. Synth. 2019, 8, 399–407. [Google Scholar] [CrossRef]
- Mostafa, H.Y.; El-Sayyad, G.S.; Nada, H.G.; Ellethy, R.A.; Zaki, E.G. Promising antimicrobial and antibiofilm activities of Orobanche aegyptiaca extract-mediated bimetallic silver-selenium nanoparticles synthesis: Effect of UV-exposure, bacterial membrane leakage reaction mechanism, and kinetic study. Arch. Biochem. Biophys. 2023, 736, 109539. [Google Scholar] [CrossRef]
- El-Behery, R.R.; El-Sayed, E.-S.R.; El-Sayyad, G.S. Gamma rays-assisted bacterial synthesis of bimetallic silver-selenium nanoparticles: Powerful antimicrobial, antibiofilm, antioxidant, and photocatalytic activities. BMC Microbiol. 2023, 23, 224. [Google Scholar] [CrossRef]
- Mirzaei, S.Z.; Somaghian, S.A.; Lashgarian, H.E.; Karkhane, M.; Cheraghipour, K.; Marzban, A. Phyco-fabrication of bimetallic nanoparticles (zinc–selenium) using aqueous extract of Gracilaria corticata and its biological activity potentials. Ceram. Int. 2021, 47, 5580–5586. [Google Scholar] [CrossRef]
- Adrianto, N.; Panre, A.M.; Istiqomah, N.I.; Riswan, M.; Apriliani, F.; Suharyadi, E. Localized surface plasmon resonance properties of green synthesized silver nanoparticles. Nano-Struct. Nano-Objects 2022, 31, 100895. [Google Scholar] [CrossRef]
- Philip, A.; Kumar, A.R. The performance enhancement of surface plasmon resonance optical sensors using nanomaterials: A review. Coord. Chem. Rev. 2022, 458, 214424. [Google Scholar] [CrossRef]
- Castro-Longoria, E.; Vilchis-Nestor, A.R.; Avalos-Borja, M. Biosynthesis of silver, gold and bimetallic nanoparticles using the filamentous fungus Neurospora crassa. Colloids Surf. B Biointerfaces 2011, 83, 42–48. [Google Scholar] [CrossRef] [PubMed]
- Jang, G.G.; Jacobs, C.B.; Gresback, R.G.; Ivanov, I.N.; Meyer, H.M., III; Kidder, M.; Joshi, P.C.; Jellison, G.E.; Phelps, T.J.; Graham, D.E.; et al. Size tunable elemental copper nanoparticles: Extracellular synthesis by thermoanaerobic bacteria and capping molecules. J. Mater. Chem. C 2015, 3, 644–650. [Google Scholar] [CrossRef]
- Sumra, A.A.; Aadil, M.; Ejaz, S.R.; Anjum, S.; Saleem, T.; Zain, M.; Alsafari, I.A. Biological synthesis of nanostructured ZnO as a solar-light driven photocatalyst and antimicrobial agent. Ceram. Int. 2022, 48, 14652–14661. [Google Scholar] [CrossRef]
- Alula, M.T.; Lemmens, P.; Bo, L.; Wulferding, D.; Yang, J.; Spende, H. Preparation of silver nanoparticles coated ZnO/Fe3O4 composites using chemical reduction method for sensitive detection of uric acid via surface-enhanced Raman spectroscopy. Anal. Chim. Acta 2019, 1073, 62–71. [Google Scholar] [CrossRef] [PubMed]
- Wiśniewska, M.; Wrzesińska, K.; Wawrzkiewicz, M.; Chibowski, S.; Urban, T.; Goncharuk, O.; Gun’ko, V.M. Alumina-silica-titania adsorbent for hazardous azo and phtalocyanine dyes removal from textile baths and wastewaters–the impact of ionic surfactants. Physicochem. Probl. Miner. Process. 2020, 56, 178–193. [Google Scholar] [CrossRef]
- Jyoti, K.; Baunthiyal, M.; Singh, A. Characterization of silver nanoparticles synthesized using Urtica dioica Linn. leaves and their synergistic effects with antibiotics. J. Radiat. Res. Appl. Sci. 2016, 9, 217–227. [Google Scholar] [CrossRef]
- Santhosh, C.; Balasubramanian, B.; Vino, P.; Viji, M.; Rejeeth, C.; Kannan, S.; Ullah, H.; Rengasamy, K.R.; Daglia, M.; Maruthupandian, A. Biofabricated selenium nanoparticles mediated from Goniothalamus wightii gains biomedical applications and photocatalytic degrading ability. J. King Saud. Univ.-Sci. 2022, 34, 102331. [Google Scholar] [CrossRef]
- Salem, S.S.; Badawy, M.S.E.; Al-Askar, A.A.; Arishi, A.A.; Elkady, F.M.; Hashem, A.H. Green biosynthesis of selenium nanoparticles using orange peel waste: Characterization, antibacterial and antibiofilm activities against multidrug-resistant bacteria. Life 2022, 12, 893. [Google Scholar] [CrossRef]
- Méndez, D.A.; Fabra, M.J.; Gómez-Mascaraque, L.; López-Rubio, A.; Martinez-Abad, A. Modelling the extraction of pectin towards the valorisation of watermelon rind waste. Foods 2021, 10, 738. [Google Scholar] [CrossRef] [PubMed]
- Karatoprak, G.Ş.; Aydin, G.; Altinsoy, B.; Altinkaynak, C.; Koşar, M.; Ocsoy, I. The Effect of Pelargonium endlicherianum Fenzl. root extracts on formation of nanoparticles and their antimicrobial activities. Enzym. Microb. Technol. 2017, 97, 21–26. [Google Scholar] [CrossRef] [PubMed]
- Ettadili, F.; Aghris, S.; Laghrib, F.; Farahi, A.; Saqrane, S.; Bakasse, M.; Lahrich, S.; El Mhammedi, M.A. Recent advances in the nanoparticles synthesis using plant extract: Applications and future recommendations. J. Mol. Struct. 2022, 1248, 131538. [Google Scholar] [CrossRef]
- Arora, N.; Thangavelu, K.; Karanikolos, G.N. Bimetallic Nanoparticles for Antimicrobial Applications. Front. Chem. 2020, 8, 412. [Google Scholar] [CrossRef] [PubMed]
- Mittal, A.K.; Kumar, S.; Banerjee, U.C. Quercetin and gallic acid mediated synthesis of bimetallic (silver and selenium) nanoparticles and their antitumor and antimicrobial potential. J. Colloid Interface Sci. 2014, 431, 194–199. [Google Scholar] [CrossRef]
- Khalil, A.M.; Hashem, A.H.; Kamel, S. Bimetallic hydrogels based on chitosan and carrageenan as promising materials for biological applications. Biotechnol. J. 2023, 2300093. [Google Scholar] [CrossRef]
- Hashem, A.H.; El-Sayyad, G.S. Antimicrobial and anticancer activities of biosynthesized bimetallic silver-zinc oxide nanoparticles (Ag-ZnO NPs) using pomegranate peel extract. Biomass Convers. Biorefinery 2023. [Google Scholar] [CrossRef]
- Padilla-Cruz, A.L.; Garza-Cervantes, J.A.; Vasto-Anzaldo, X.G.; García-Rivas, G.; León-Buitimea, A.; Morones-Ramírez, J.R. Synthesis and design of Ag–Fe bimetallic nanoparticles as antimicrobial synergistic combination therapies against clinically relevant pathogens. Sci. Rep. 2021, 11, 5351. [Google Scholar] [CrossRef]
- Merugu, R.; Garimella, S.; Velamakanni, R.; Vuppugalla, P.; Chitturi, K.L.; Jyothi, M. Synthesis, characterization and antimicrobial activity of bimetallic silver and copper nanoparticles using fruit pulp aqueous extracts of Moringa oleifera. Mater. Today Proc. 2021, 44, 153–156. [Google Scholar] [CrossRef]
- Sivamaruthi, B.S.; Ramkumar, V.S.; Archunan, G.; Chaiyasut, C.; Suganthy, N. Biogenic synthesis of silver palladium bimetallic nanoparticles from fruit extract of Terminalia chebula—In Vitro evaluation of anticancer and antimicrobial activity. J. Drug Deliv. Sci. Technol. 2019, 51, 139–151. [Google Scholar] [CrossRef]
- Singh, C.; Mehata, A.K.; Priya, V.; Malik, A.K.; Setia, A.; Suseela, M.N.L.; Vikas; Gokul, P.; Samridhi; Singh, S.K.; et al. Bimetallic Au-Ag Nanoparticles: Advanced Nanotechnology for Tackling Antimicrobial Resistance. Molecules 2022, 27, 7059. [Google Scholar] [CrossRef]
- Jena, P.; Bhattacharya, M.; Bhattacharjee, G.; Satpati, B.; Mukherjee, P.; Senapati, D.; Srinivasan, R. Bimetallic gold–silver nanoparticles mediate bacterial killing by disrupting the actin cytoskeleton MreB. Nanoscale 2020, 12, 3731–3749. [Google Scholar] [CrossRef]
- Slavin, Y.N.; Asnis, J.; Häfeli, U.O.; Bach, H. Metal nanoparticles: Understanding the mechanisms behind antibacterial activity. J. Nanobiotechnol. 2017, 15, 65. [Google Scholar] [CrossRef] [PubMed]
- Zhao, X.; Drlica, K. Reactive oxygen species and the bacterial response to lethal stress. Curr. Opin. Microbiol. 2014, 21, 1–6. [Google Scholar] [CrossRef] [PubMed]
- Khalil, A.M.A.; Abdelaziz, A.M.; Khaleil, M.M.; Hashem, A.H. Fungal endophytes from leaves of Avicennia marina growing in semi-arid environment as a promising source for bioactive compounds. Lett. Appl. Microbiol. 2021, 72, 263–274. [Google Scholar] [CrossRef]
- Ioset, J.-R.; Brun, R.; Wenzler, T.; Kaiser, M.; Yardley, V. Drug Screening for Kinetoplastids Diseases: A Training Manual for Screening in Neglected Diseases; Drugs for Neglected Diseases Initiative: Geneva, Switzerland, 2009; 74p. [Google Scholar]
- Nieto-Argüello, A.; Medina-Cruz, D.; Pérez-Ramírez, Y.S.; Pérez-García, S.A.; Velasco-Soto, M.A.; Jafari, Z.; De Leon, I.; González, M.U.; Huttel, Y.; Martínez, L. Composition-dependent cytotoxic and antibacterial activity of biopolymer-capped ag/au bimetallic nanoparticles against melanoma and multidrug-resistant pathogens. Nanomaterials 2022, 12, 779. [Google Scholar] [CrossRef] [PubMed]
- Elsayed, K.A.; Alomari, M.; Drmosh, Q.A.; Alheshibri, M.; Al Baroot, A.; Kayed, T.S.; Manda, A.A.; Al-Alotaibi, A.L. Fabrication of ZnO-Ag bimetallic nanoparticles by laser ablation for anticancer activity. Alex. Eng. J. 2022, 61, 1449–1457. [Google Scholar] [CrossRef]
- Katifelis, H.; Mukha, I.; Bouziotis, P.; Vityuk, N.; Tsoukalas, C.; Lazaris, A.C.; Lyberopoulou, A.; Theodoropoulos, G.E.; Efstathopoulos, E.P.; Gazouli, M. Ag/Au bimetallic nanoparticles inhibit tumor growth and prevent metastasis in a mouse model. Int. J. Nanomed. 2020, 15, 6019–6032. [Google Scholar] [CrossRef]
- Ghosh, N.; Singh, R. In vitro cytotoxicity assay of biogenically synthesized bimetallic nanoparticles. Rasayan J. Chem. 2021, 14, 486–492. [Google Scholar] [CrossRef]
- Juan, C.A.; Pérez de la Lastra, J.M.; Plou, F.J.; Pérez-Lebeña, E. The Chemistry of Reactive Oxygen Species (ROS) Revisited: Outlining Their Role in Biological Macromolecules (DNA, Lipids and Proteins) and Induced Pathologies. Int. J. Mol. Sci. 2021, 22, 4642. [Google Scholar] [CrossRef]
- Ghosh, R.; Goswami, U.; Ghosh, S.S.; Paul, A.; Chattopadhyay, A. Synergistic anticancer activity of fluorescent copper nanoclusters and cisplatin delivered through a hydrogel nanocarrier. ACS Appl. Mater. Interfaces 2015, 7, 209–222. [Google Scholar] [CrossRef] [PubMed]
- Tabish, T.A.; Hamblin, M.R. Mitochondria-targeted nanoparticles (mitoNANO): An emerging therapeutic shortcut for cancer. Biomater. Biosyst. 2021, 3, 100023. [Google Scholar] [CrossRef] [PubMed]
- Alsaab, H.O.; Al-Hibs, A.S.; Alzhrani, R.; Alrabighi, K.K.; Alqathama, A.; Alwithenani, A.; Almalki, A.H.; Althobaiti, Y.S. Nanomaterials for Antiangiogenic Therapies for Cancer: A Promising Tool for Personalized Medicine. Int. J. Mol. Sci. 2021, 22, 1631. [Google Scholar] [CrossRef]
- Ali, O.M.; Hasanin, M.S.; Suleiman, W.B.; Helal, E.E.-H.; Hashem, A.H. Green biosynthesis of titanium dioxide quantum dots using watermelon peel waste: Antimicrobial, antioxidant, and anticancer activities. Biomass Convers. Biorefinery 2022. [Google Scholar] [CrossRef]
- Jebril, S.; Jenana, R.K.B.; Dridi, C. Green synthesis of silver nanoparticles using Melia azedarach leaf extract and their antifungal activities: In Vitro and In Vivo. Mater. Chem. Phys. 2020, 248, 122898. [Google Scholar] [CrossRef]
- Teeling, E.C.; Springer, M.S.; Madsen, O.; Bates, P.; O'Brien, S.J.; Murphy, W.J. A molecular phylogeny for bats illuminates biogeography and the fossil record. Science 2005, 307, 580–584. [Google Scholar] [CrossRef] [PubMed]
- National Committee for Clinical Laboratory Standards. Reference Method for Broth Dilution Antifungal Susceptibility Testing of Yeasts; National Committee for Clinical Laboratory Standards: Wayne, PA, USA, 2002. [Google Scholar]
- Valgas, C.; Souza, S.M.D.; Smânia, E.; Smânia, A. Screening methods to determine antibacterial activity of natural products. Braz. J. Microbiol. 2007, 38, 369–380. [Google Scholar] [CrossRef]
- Van de Loosdrecht, A.; Beelen, R.; Ossenkoppele, g.; Broekhoven, M.; Langenhuijsen, M. A tetrazolium-based colorimetric MTT assay to quantitate human monocyte mediated cytotoxicity against leukemic cells from cell lines and patients with acute myeloid leukemia. J. Immunol. Methods 1994, 174, 311–320. [Google Scholar] [CrossRef]

| Test Microbial Strain | Se (IZ) | Ag (IZ) | Se-Ag NPs | SAM/NS | ||
|---|---|---|---|---|---|---|
| IZ/mm | MIC (µg/mL) | IZ/mm | MIC (µg/mL) | |||
| E. coli | ND | ND | 14.33 ± 0.58 | 50 | 10.33 ± 0.58 | 100 |
| P. aeruginosa | ND | ND | 18.87 ± 0.76 | 12.5 | ND | ND |
| K. oxytoca | ND | ND | 20.00 ± 1.00 | 12.5 | ND | ND |
| B. subtilis | ND | ND | 16.17 ± 0.76 | 25 | 12.17 ± 1.04 | 50 |
| S. aureus | ND | ND | 17.17 ± 1.26 | 12.5 | ND | ND |
| C. albicans | ND | ND | 12.27 ± 1.42 | 50 | ND | ND |
Disclaimer/Publisher’s Note: The statements, opinions and data contained in all publications are solely those of the individual author(s) and contributor(s) and not of MDPI and/or the editor(s). MDPI and/or the editor(s) disclaim responsibility for any injury to people or property resulting from any ideas, methods, instructions or products referred to in the content. |
© 2023 by the authors. Licensee MDPI, Basel, Switzerland. This article is an open access article distributed under the terms and conditions of the Creative Commons Attribution (CC BY) license (https://creativecommons.org/licenses/by/4.0/).
Share and Cite
Hashem, A.H.; El-Sayyad, G.S.; Al-Askar, A.A.; Marey, S.A.; AbdElgawad, H.; Abd-Elsalam, K.A.; Saied, E. Watermelon Rind Mediated Biosynthesis of Bimetallic Selenium-Silver Nanoparticles: Characterization, Antimicrobial and Anticancer Activities. Plants 2023, 12, 3288. https://doi.org/10.3390/plants12183288
Hashem AH, El-Sayyad GS, Al-Askar AA, Marey SA, AbdElgawad H, Abd-Elsalam KA, Saied E. Watermelon Rind Mediated Biosynthesis of Bimetallic Selenium-Silver Nanoparticles: Characterization, Antimicrobial and Anticancer Activities. Plants. 2023; 12(18):3288. https://doi.org/10.3390/plants12183288
Chicago/Turabian StyleHashem, Amr H., Gharieb S. El-Sayyad, Abdulaziz A. Al-Askar, Samy A. Marey, Hamada AbdElgawad, Kamel A. Abd-Elsalam, and Ebrahim Saied. 2023. "Watermelon Rind Mediated Biosynthesis of Bimetallic Selenium-Silver Nanoparticles: Characterization, Antimicrobial and Anticancer Activities" Plants 12, no. 18: 3288. https://doi.org/10.3390/plants12183288
APA StyleHashem, A. H., El-Sayyad, G. S., Al-Askar, A. A., Marey, S. A., AbdElgawad, H., Abd-Elsalam, K. A., & Saied, E. (2023). Watermelon Rind Mediated Biosynthesis of Bimetallic Selenium-Silver Nanoparticles: Characterization, Antimicrobial and Anticancer Activities. Plants, 12(18), 3288. https://doi.org/10.3390/plants12183288









